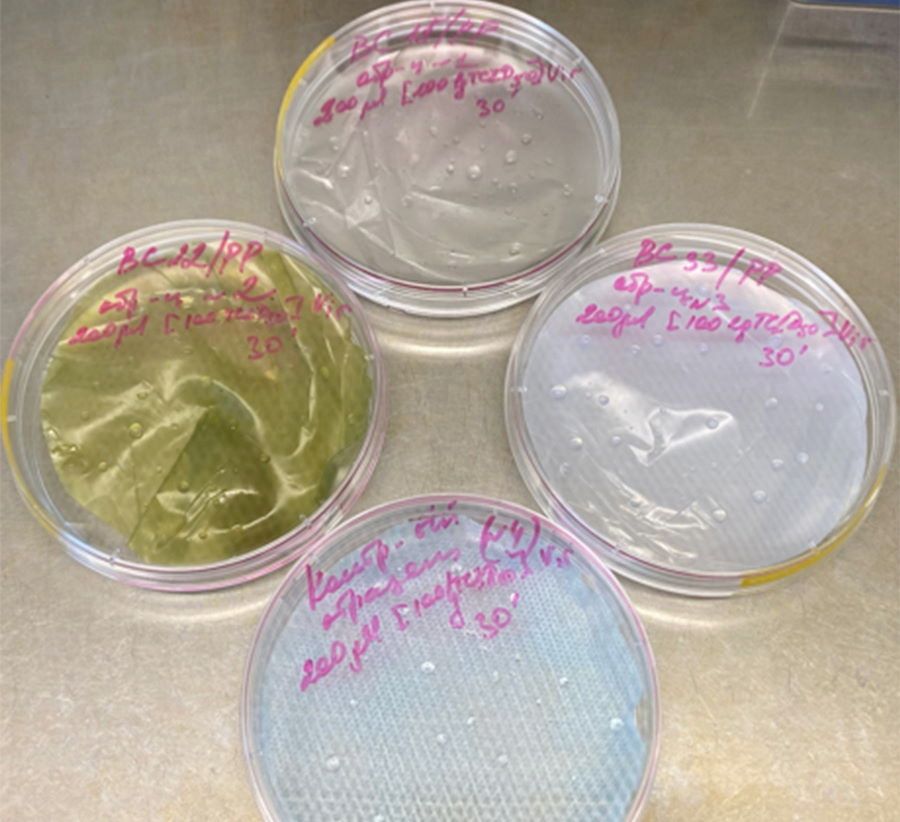
Образование и наука, ТГУ, Томские новости, тгу маски вирусы защита наночастицы безопасность покрытие для масок Томские ученые испытали новые материалы с наночастицами для защитных масок

Томские ученые испытали новые материалы с наночастицами для защитных масок
Разработанные томскими учеными новые материалы с бактерицидным и вирулицидным эффектом, которые могут применяться для защитных масок и медицинской одежды, успешно прошли тестирование, сообщает пресс-служба Томского госуниверситета.
Материалы, созданные при содействии ТГУ, Института физики прочности и материаловедения СО РАН и Инжинирингового химико-технологического центра, были испытаны на базе Федерального исследовательского центра фундаментальной и трансляционной медицины (ФИЦ ФТМ, Новосибирск) в соответствии с самыми современными протоколами оценки противовирусной активности с использованием модели вируса гриппа A/H1N1 и протестированы в ИФПМ СО РАН (Томск) на модели Escherichia coli (кишечная палочка). Новые материалы показали высокую эффективность в отношении обоих модельных объектов.
«Ситуация с новыми патогенами, возникающими из природных очагов, требует принципиально нового подхода к организации профилактики: необходимо создавать барьеры на пути распространения микробов путем предотвращения их накопления на поверхностях и медицинских изделиях, — объясняет советник при ректорате ТГУ Алексей Сазонов. — Последние случаи вспышек вируса атипичной пневмонии, птичьего гриппа, гриппа H1N1, коронавируса COVID-19 показали, что недостаточно обрабатывать поверхности дезинфектантами. Необходимо, чтобы поверхности сами „боролись“ с инфекцией».
Учёные ТГУ и ИФПМ СО РАН разработали новые технологии придания антисептических свойств полимерным медицинским материалам, включая волокнистые, используемые для изготовления защитных масок, халатов, шапочек и других предметов медицинского назначения. В качестве инструмента, выступающего преградой для возбудителя, учёные использовали наночастицы оксида цинка и биокомпонентные частицы оксида меди (Cu-Fe)O, полученные методом электрического взрыва проводников.
В ходе исследований на базе ФИЦ ФТМ были протестированы образцы волокнистых структур: несколько образцов полипропилена с частицами меди, оксида меди и оксида цинка, а также контрольные образцы — фрагменты нетканого материала спанбонда.
На материалы наносили жидкость, содержащую штаммы пандемического модельного вируса гриппа A/Tomsk/273-MA1/2010(H1N1pdm09). По прошествии 30 минут исследователи оценивали вирусную нагрузку в смывах с материалов. В смывах с образцов полипропилена, содержащих частицы оксида меди и оксида цинка, вирусная нагрузка отсутствовала, в отличие от смыва с поверхности контрольного образца (спанбонд), где отмечено высокое содержание вируса.
Наряду с этим противовирусную активность материалов с наночастицами тестировали на культуре клеток MDCK, чувствительных к вирусу. Их обрабатывали жидкостями со смывов и оценивали жизнеспособность клеток. Анализ показал, что смывы с наноматерилов не оказали отрицательного воздействия на клетки, в отличие от смывов с контрольного образца (спанбонд), не содержащего наночастицы.
В ходе исследований, проведённых сотрудниками ТГУ и ИФПМ СО РАН, была выявлена эффективность защитных свойств новых материалов в отношении кишечной палочки. Наряду с этим установлено, что технологические процессы не оказывают отрицательного влияния на биоактивные частицы и не снижают их защитные качества.
«Результаты испытаний позволили нам по-новому взглянуть на собственную разработку, — говорит проректор ТГУ по научной и инновационной деятельности Александр Ворожцов. — Полученные нами наночастицы перспективны для применения и в других областях. Например, их можно вводить в лакокрасочные материалы и использовать для обработки поверхностей в медицинских учреждениях, школах, детских садах и других организациях с большой проходимостью. Сейчас для таких целей иногда применяются серебросодержащие краски. Краски с нашими наночастицами будут не только эффективны, но и кратно дешевле. Благодаря таким покрытиям процесс дезинфекции станет постоянным. В настоящее время ТГУ с партнёрами решает вопросы коммерциализации нового продукта и вывода его на рынок».
Стоит отметить, что высокоэффективные и нетоксичные материалы и изделия из них (дверные ручки, поверхности столов, плинтусы, лицевые маски, одежда медперсонала, перчатки и др.), позволяющие прервать пути распространения инфекций, крайне востребованы в здравоохранении. Более того, эти материалы могут использоваться и в быту, защищая людей в режиме 24/7. Ярким примером могут стать корпуса сотовых телефонов с бактерицидным и вирулицидным эффектом, которые в настоящее время являются чуть ли не основным «транспортным средством» для патогенов.
Подписывайтесь на наш телеграм-канал «Томский Обзор».